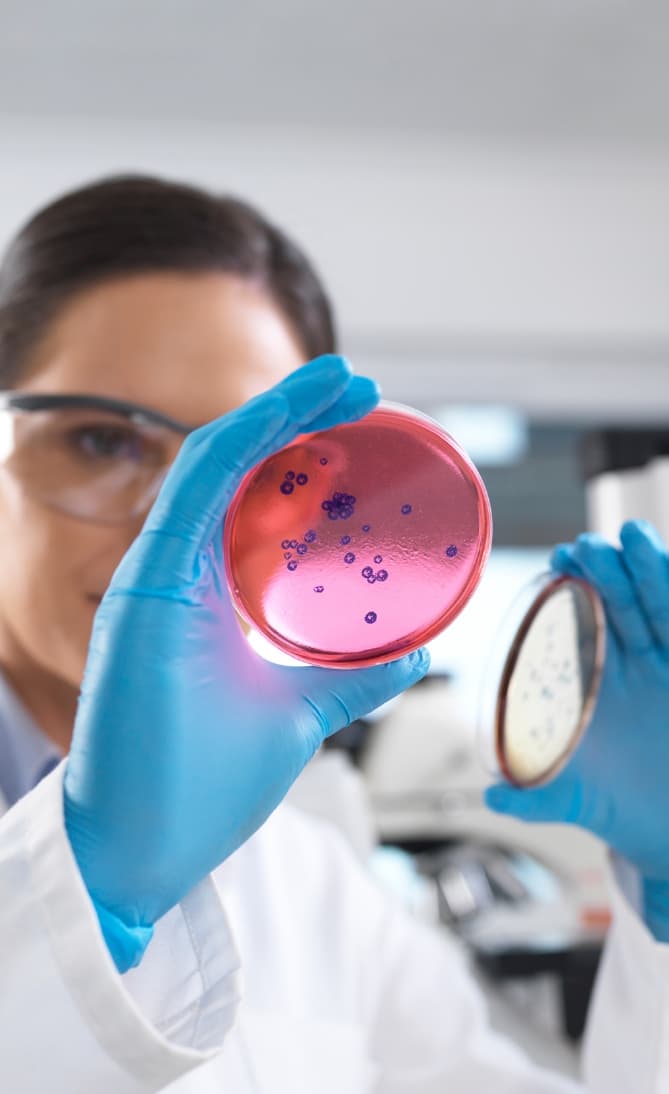
Laboratorio de patología

Laboratorio de patología
A cargo de un médico especialista en Anatomía Patológica, junto a un equipo multidisciplinario de profesionales de la salud como tecnología medica, técnico en laboratorio de Anatomía Patológica realizan el procesamiento, y el medico especialista a cargo el análisis de muestras obtenidas por exfoliación, biopsias incisionales, escicionales, dirigida a mujeres y varones con el finprevención, diagnóstico , manejo y pronóstico de patologías entre otros servicios.
Diagnosticos como:
- • Citopatología
- • Histología
- • Biopsias Con Aguja Fina
- • Inmunohistoquímica
- • Patología Molecular: PCR Para Papiloma Virus Humano